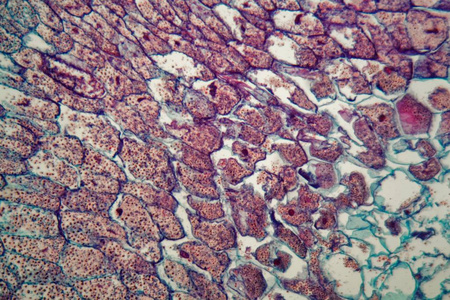
截面显微镜显微镜下玉米幼苗细胞的横截面照片

玉米叶表皮细胞图

331玉米叶横切10x6
图片尺寸800x634
玉米叶横切
图片尺寸708x486
玉米叶横切
图片尺寸600x600
玉米叶横切水稻叶表皮装片向日葵花纵切荠菜幼胚切片荠菜成熟胚切片梨
图片尺寸1024x768
查看答案 叶的表皮细胞一般透明,不含叶绿体,细胞液无色,这对叶的
图片尺寸477x317
玉米叶横切
图片尺寸300x225
玉米叶肉细胞是指玉米叶片位于上,下表皮之间栅栏组织和海绵
图片尺寸350x196
图9-3 玉米叶横切面1.表皮;2.叶肉;3.叶脉;4.木质部;5.韧皮部;6.
图片尺寸774x463
334玉米叶横切示花环型维管束6
图片尺寸800x634
100倍数下的玉米叶下表皮
图片尺寸1500x1529
毛茛老根横切面(部分)玉米叶横切(部分)
图片尺寸254x162
下观察单子叶植物玉米茎横切的装片,可以看到茎的表面有一层表皮,表皮
图片尺寸600x257
结构特点细胞排列紧密无色透明(2)②和④合称叶肉.
图片尺寸339x207
玉米核显微镜下玉米幼苗细胞的横截面.照片
图片尺寸450x300
玉簪叶下表皮装片 - 细胞与组织-植物学生物切片-产品展示 - 河南大科
图片尺寸600x444
单子叶植物茎横切(玉米,200×)①表皮 ②韧皮部 ③木质部 ④薄壁细胞
图片尺寸455x289
截面显微镜显微镜下玉米幼苗细胞的横截面照片
图片尺寸450x300
第一节生物体的基本结构 洋葱鳞片叶内表皮细胞 细胞壁 细胞质 细胞核
图片尺寸1080x810
单子叶植物茎横切草本植物茎玉米茎横切生物切片标本
图片尺寸750x410
截面显微镜显微镜下玉米茎细胞的横截面照片
图片尺寸450x300